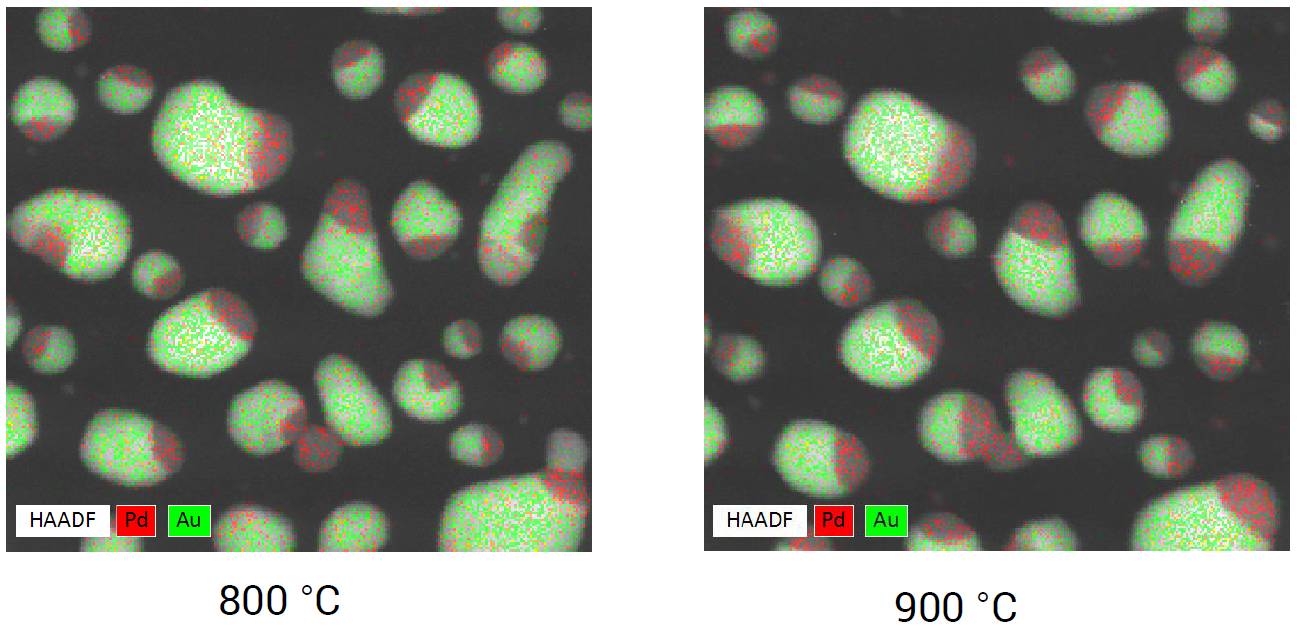

引言
最近,Lighting Arctic 原位冷冻热电样品杆上市,将原位热电技术推向新的高度,使其在能源转换、材料研究等领域发挥更大作用。
细心的读者朋友可能已经发现了,从第一款产品 Wildfire 原位加热样品杆开始,到最近的 Lightning Arctic 原位冷冻热电样品杆,变温过程中的稳定性始终是 DENS 系列产品的一大特点。事实上也确实如此,得益于先进的 MEMS (微机电系统) 技术和创新的设计理念,DENS 原位样品杆优秀的温控性和稳定性经过了时间的考验,为原位实验技术的发展提供了保障,也得到了许多用户的认可。下面,我们将以 Wildfire 原位加热样品杆为例,从控温精准、图像稳定、高温 EDS (能谱)分析、加热均匀这四个方面,向大家更全面地介绍 透射电镜原位样品杆在加热功能上所具有的特性。
原位样品杆芯片加热原理
在详细介绍之前,先和大家介绍一下 Wildfire 原位样品杆加热芯片的加热原理。芯片采用电阻式加热法为目标区域提供热量,以达到所需温度,即通过将电能转换成热能来加热物体,这和日常生活中电热毯、电热炉(图 1)的工作原理是一致的。只不过 Wildfire 原位加热样品杆是对 MEMS 芯片上的微米级区域进行加热,它的功率要小很多,在毫瓦量级,仅相当于电热炉的百万分之一!


图 1:电热炉的加热线圈(上)和 MEMS 芯片上的加热线圈(下)
原位样品杆加热特性
特性 1:控温精准
现在,大家对于原位样品杆的加热原理有了一定了解。那自然会好奇,原位样品杆到底是如何使加热区达到指定温度的呢?
回想高中物理知识,大家或许还记得金属的电阻随着温度的升高而增大。实际上,金属电阻和温度成线性关系(图 2),而直线斜率就是电阻温度系数 (Temperature Coefficient of Resistance, 简称 TCR)。知道了 TCR 和某一温度下的电阻,我们就可以确定温度与电阻的对应关系。在这种情况下,温度数值和电阻数值一一互相对应。知道了电阻,就可以计算出温度,反之亦然。

图 2:电阻和温度呈线性关系
那我们是如何测量加热区域的电阻呢,其实还是我们在物理课堂上所学的电阻计算公式:
电阻=电压/电流
只不过,Wildfire 加热芯片对于电阻的测量采用了一种更为准确的方式——四探针法(图3左)。相较于传统的测量方法(图 3 右),四探针法因为就近额外设置了两个触点,可以更直接地测量线圈(Rheater)的电压,避免引入回路中接触电阻(Rcontact)、导线电阻(Rcable、Rwires)等的电压。由此所测得的电压才是真正的线圈电压,从而计算出来的电阻也就是准确的线圈阻值。

图 3:四探针法测电阻(左)和传统测量方法(右)


图 4:Wildfire 原位样品杆加热芯片,采用四电极设计
每一组加热芯片在出厂时,都经过了校准测试,并计算出了独立的 TCR 值和R0 (室温时的线圈电阻)。知道了 TCR 和 R0,就可以确定微线圈的电阻-温度关系,再加上用四探针法所准确测量的电阻值,我们就可以知道加热线圈当前的准确温度。
当我们把样品固定在芯片上开始实验时,微线圈通过上述方式对样品进行加热。在升温过程中,线圈和样品发生热量交换。样品受热时可能会由于结构、成分变化,给加热过程带来动态干扰。为了进一步确保温度的准确和稳定,我们引入了闭环反馈机制(Closed Loop Feedback Mechanism, 图 5),用来实时响应温度波动,瞬间做出功率调整,最终可以达到 0.005 ºC 的温度稳定性。

图 5:四电极(二加热&二感知),加热线圈(左)和闭环反馈机制(右)
此外,这种机制也有助于实现快速且准确的变温,为探究变温过程中的结构变化带来了极大便利(图 6)。

图 6:在 300ºC 和 400ºC 之间往复变温,Cu3Au 在简立方相(SC)和面心立方相(FCC)之间发生可逆相变(相变点 390ºC)。借助选区电子衍射(SAED)可以直接观察到两种相的反复切换。
特性 2:稳定的高温图像
目前市面上主流的原位透射电镜加热方案都采用芯片式设计,为了避免加热器与样品接触发生化学反应或加热电流流经样品,一般都会在加热器上包覆一层超薄氮化硅(SiN)薄膜用以和样品隔离。温度改变时,SiN 薄膜会发生鼓包变形,薄膜上承载的样品也会跟着发生位移,焦距会变化,进而图像模糊,甚至样品可能会漂出视野。
得益于独家专利,DENSsolutions 优化设计的加热芯片在室温至 500 ºC 区间内的焦距变化不超过 300 nm。在此范围内,用户只需再次稍微调焦即可恢复图像清晰度。实际上,目前采用最新设计的新款芯片要比它的上一代产品的鼓包变形要小得多(图 7),在 500 ºC 以内变形可以忽略不计,即使到了 1300 ºC 形变量也不到 7 μm。

图 7:采用了最新设计的芯片(左)比上一代芯片(右)的受热鼓包形变更小。
相反,如果是未经优化设计的普通芯片,才刚加热到 200 ºC 时,焦距变化就远大于 200 nm,用户就不得不移动样品台的物理 Z 轴来补偿该变化。这种操作比较耗时,很可能会错过重要的反应过程。如果不移动、只调焦的话,则可能会带来像差,进而影响图像质量。
鼓包不仅会带来 Z 方向上的焦距变化,也会引起 X、Y 方向上的图像漂移。原位实验研究某一颗粒或某一微区时,需要在整个温度变化过程中都可以观察到目标区域。漂移较小所带来的好处就是——即使升温再高,样品始终在视野范围内,还可以被观察到(图 8)。否则,升到某一温度时颗粒就可能漂出视野,不移动样品台就无法找到样品。如果漂移再多、再快的话,即使操作样品台也永远无法找到这个样品了。

图 8:即使升温至 1300 ºC 后,所关注的纳米颗粒依旧在视野中。
Wildfire 原位加热杆加热样品时,漂移率小于 0.5 nm/min,升温至 350 ºC 时漂移小于 20 nm (视频 1),升温至 1000 ºC 时漂移小于 200 nm。
特性 3:高温 EDS 分析
进行 EDS (能量分散谱,即能谱)分析时,探测器采集来自样品的特征 X 射线,转换成电压信号进行分通道计数,根据不同能量 X 射线对应的计数量,可以得出各元素的百分含量。从原理上讲,其他电磁波诸如红外线、可见光、紫外线也可以激发 EDS 探测器,带来计数量,但 EDS 不能用这些计数进行有效分析。
线圈温度上升时会发光发热,也就是会产生可见光和红外线。这些额外的电磁波会被 EDS 探测器接收,产生大量无效计数,甚至淹没关键的特征 X 射线计数,使计数器达到饱和上限,导致无法进行有效分析。要想在加热的同时实现可靠的高温 EDS 分析,就要尽量减少热辐射的产生。

图 9:EDS 探测器构造,可以看到晶体后方连着传感器和冷阱,以保证低温。
得益于先进的 MEMS 设计,Wildfire 芯片仅需要毫瓦级的功率即可对微区进行精确可靠的温度控制。如此小的加热功率,它所产生的红外辐射自然也是少之又少的。因此,即便在更高的温度下,依旧可以获得可靠的 EDS 结果。
图 10:高温下 Au/Pd 纳米颗粒的 EDS 面扫结果
特性 4:温度均匀一致
前文我们提到,微线圈的加热原理是把电能转换成热能。这种焦耳生热的效率与电阻有关——电阻越大产生的热量就越多。下图中我们可以看到,加热线圈外围导线明显较细,而内圈导线较宽。这样外围线圈产生的热量较多,内圈产生的热量较少,一定程度上可以抵消由中心向外围的温度梯度。如果是导线粗细一致,产生热量相同,毫无疑问中心温度会更高,自然就会有由内向外的温度由高到低的梯度。采用这样的设计,加热区域的温度均匀性也就无法得到保证。

图 11:Wildfire 芯片加热区的线圈排布和温度均匀性分布
通过这种线圈设计方式,全区域温度一致性优于 98%。甚至,在最中心的两个圆形窗口,温度一致性高达 99.5%!